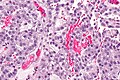
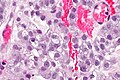

Clear cell carcinoma of the vagina
Jump to navigation
Jump to search
Clear cell carcinoma of the vagina is a very rare epithelial malignancy of the vagina.[1]
General
- Often lumped the clear cell carcinoma of the uterine cervix.[1]
Microscopic
Images
Case
www
Sign out
VAGINAL VAULT, BIOPSY: - CLEAR CELL CARCINOMA, SEE COMMENT. COMMENT: The tumour stains as follows: POSITIVE: CK7, CAM5.2, PAS. NEGATIVE: ER, PR, p53, p16, WT-1, PASD. PROLIFERATION: ~60%.
Micro
The sections show a tumour with a papillary cystic architecture that is composed of moderately atypical monomorphic cells with moderate pale grey cytoplasm. Focal cytoplasmic clearing is present. Hobnailing is present focally. The nucleoli are not prominent.
See also
References
- ↑ 1.0 1.1 Ansari, DO.; Horowitz, IR.; Katzenstein, HM.; Durham, MM.; Esiashvili, N. (Jul 2012). "Successful treatment of an adolescent with locally advanced cervicovaginal clear cell adenocarcinoma using definitive chemotherapy and radiotherapy.". J Pediatr Hematol Oncol 34 (5): e174-6. doi:10.1097/MPH.0b013e318257dc91. PMID 22713709.